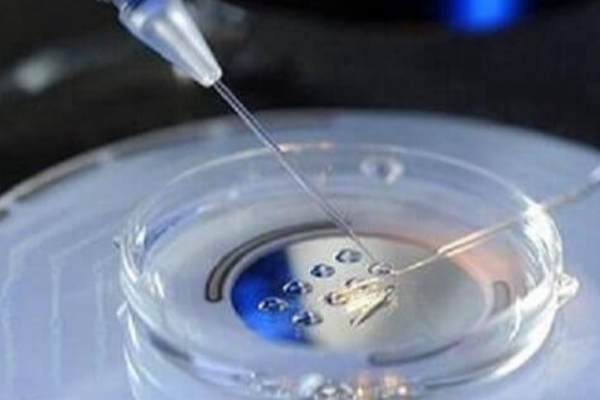

在试管婴儿技术中,鲜胚与冻胚移植的成功率常引发患者关注。临床数据显示,两者成功率并无绝对高低之分,需结合患者年龄、卵巢功能、子宫内膜状态等综合判断。
一、鲜胚与冻胚移植成功率对比
鲜胚移植指取卵后直接将胚胎移植至子宫,其优势在于避免冷冻解冻过程对胚胎的潜在损伤,但成功率易受母体激素水平波动影响。例如,卵巢过度刺激综合征患者若强行鲜胚移植,成功率可能降至30%以下。冻胚移植则通过冷冻技术保存胚胎,待母体激素水平稳定、子宫内膜容受性最佳时再移植,成功率通常在50%-60%之间。研究显示,35岁以下女性冻胚移植成功率可达55%,而鲜胚移植成功率约为45%;但40岁以上女性因卵巢功能衰退,冻胚移植成功率优势更明显,可达40%,鲜胚则仅25%左右。
二、复苏移植的常见问题解析
1、复苏移植方案选择
常用方案包括自然周期、激素替代周期和促排卵周期。自然周期适用于月经规律者,通过监测排卵确定移植时间;激素替代周期通过外源性激素调控子宫内膜,适合排卵障碍者;促排卵周期则通过药物增加卵泡数量,提高胚胎选择空间,但需警惕多胎妊娠风险。
2、复苏移植时间安排
激素替代周期通常需3周左右,待子宫内膜厚度达8mm以上、血雌二醇水平达标后,再使用黄体酮转化内膜,随后根据胚胎类型(如第3天卵裂期胚胎或第5天囊胚)确定移植时机。
3、复苏移植风险与应对
胚胎冷冻解冻过程可能造成1%-2%的胚胎损伤,但现代玻璃化冷冻技术已将风险大幅降低。移植后需严格遵循医嘱进行黄体支持,避免剧烈运动,并保持情绪稳定。若出现腹痛、出血等症状,需及时就医排查并发症。
三、临床建议
年轻、卵巢功能良好且子宫内膜状态理想的患者可优先考虑鲜胚移植;而高龄、卵巢储备功能下降或需调整内分泌环境者,冻胚移植成功率更高。无论选择何种方式,均需与医生充分沟通,结合个体化方案优化移植时机,以最大化提升妊娠成功率。








